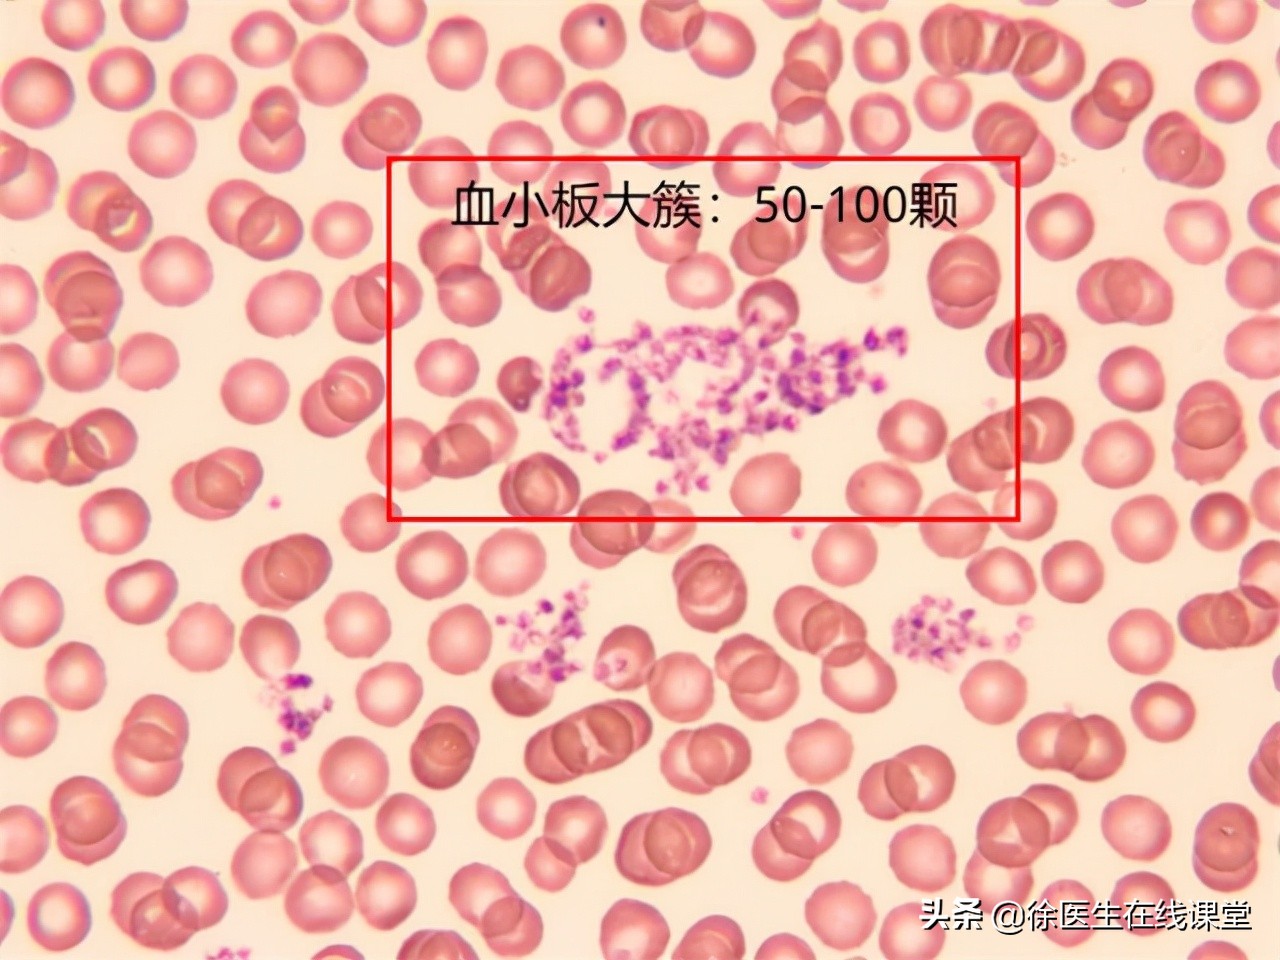
血粘度高吃脂必妥管用吗,血粘度偏高吃阿司匹林吃多久停药

随着现代医学的不断进步,常见的急慢性疾病都有了成熟的治疗方案,同时,亚健康这一威胁就渐渐进入了人们的视线。亚健康状态不容易被人体感知,其轻微症状在久经忽视之后,就有可能引发一系列的严重疾病。
血液粘稠度 就是这样一项容易被忽视的指标,它不像“三高”一样让人谈之色变,却与其有着紧密的联系,是心绞痛、脑梗等多种疾病的危险因素。

今年56岁的吴女士一直维持着定期体检的习惯,身体的各项指标也都正常。最近,她早晨起床后总是头晕,每天回家上楼也有气喘、力竭的感觉,她认为这是年龄增长的自然表现,但是在本年初例行体检,报告中显示她的血液粘稠度过高。
因为当时她的身体已经有明确的症状,医生为她输液治疗了一周的时间,并配合服用阿司匹林,血粘的症状得到了缓解。
吴女士感觉非常好,此后每个三个月就服用两盒阿司匹林,隔半年有机会,就会按照原本的处方去诊所输液,她认为这是维持健康的有效措施,之后的几次血常规检查,一切指标也恢复了正常。
但是,这种通过服药维持的血粘度,真的对身体没有任何损害吗?

一、对血粘度的认知
血液粘稠度,是血常规化验中的一项,来源于血液中分子和颗粒之间的摩擦。更为细致的检查会分为全血粘度和血浆粘度,全血粘度主要取决于血细胞的比容——即固定体积血液中的细胞数量;血浆粘度取决于血浆蛋白的含量。
人体依靠血液为各个器官、组织运输和灌注营养物质,带走代谢废物,像是一道道“运输管网”,维持着组织细胞的活力。血液在血管内的顺畅流动,就像是道路的畅通无阻,显得尤为重要。
和血液粘稠度直接相关的,就是血流速度,他们两者是互相影响的。
血液粘稠,就像是一杯清水变成了浓汤,相同的动力下,流动的速度必然减慢。
而当某些疾病因素,使微循环处的血流速度明显减慢时,原本正常的血液即会发生血细胞的叠连和聚集。这些原本大小适宜的细胞,聚集成了移动困难的团块,与血管壁、以及其它细胞之间的摩擦加大,血液的粘度就此增加。
而粘度增加,反过来再次加重了血流过缓,如果不能得到机体的有效调节,就容易形成血栓。
血粘度增高的后果,就是对毛细血管的损伤,以及对各处器官和组织的供血不足。
1.对 脑部血管供血不足 ,会造成思维和精神方面的抑制。比如 晨起头晕,思维迟钝;午餐后犯困, 必须午休才能保证下午的精力;晚餐之后精力充沛,甚至对入睡造成困扰。
2. 对心肺器官供血不足 ,表现为略微剧烈运动后的气喘,身体处于蹲位时呼吸困难,猛然站起时眼前发黑。对眼部血管供血不足,导致阵发性的视物模糊。人体的视神经得不到充分的滋养,逐渐由偶发性的视力下降,发展为长期的视觉障碍。
3.伤害和堵塞血管。 毛细血管分布于身体各处,因为过于细微而十分容易被破坏。粘稠的血液摩擦、沉积于血管壁,造成血管硬化,斑块处也更加容易吸附脂质和钙,长期的负面效应叠加,最后形成堵塞。

堵塞的血管无法为指定的组织供应营养,周边细胞会率先萎缩、死亡,导致组织器官功能受损:脑部表现为头痛健忘、脱发失眠;关节处表现为腰痛和肩膀发酸;皮肤上显现出水肿、色斑和皱纹;对女性来讲,还会引发月经不调、痛经的症状。
长期血粘度过高,损害就不仅仅局限于毛细血管了,损伤和斑块会发展到以心脑血管为代表的狭窄动脉,甚至造成脑卒中和心肌梗死的严重后果。
二、定期服药和输液能预防血栓和心脑血管疾病?医生这样说

首先, 血栓和心梗、脑梗等心脑血管疾病是存在先后关系的 。
心脑动脉血管的特定部位上,首先要形成加速物质凝集的斑块,一段时间后形成血栓;血栓的体积逐渐增长,直接堵塞血管通路,或者因为某些外力的刺激脱落,随血液前进时卡在更为狭窄的位置,堵死血管。这就是我们常说的心肌梗死和脑卒中。
其次, 血粘度高只是心脑血管疾病的一个危险因素,没有必然的关系。
更多时候,血粘度高只是血压、血糖和血脂过高的一个外在表现,引发此类疾病的原因在于“三高”,我们应当把治疗的重点放在这里,单纯为降低血粘度而用药,预防和治疗作用非常受限。

另外, 引发心脑血管疾病的血栓多为动脉粥样硬化性血栓。
它是以胆固醇、甘油三酯等为主要物质,并作为内核而吸附凝集的。若以预防心脑血管疾病为目的,仅注意血粘度一项是不够的。
医生为吴女士开具的处方,是银杏达莫注射液和阿司匹林肠溶片,银杏达莫注射液需要一定量的生理盐水稀释,再通过输液缓慢滴注进人体血液。

两种药物对人体血液的作用原理不同,但作用是相似的。
银杏达莫含有银杏总黄酮,可以扩张冠状动脉和脑血管,是血液通路更宽阔;双嘧达莫可以抑制血小板聚集,防止形成血栓,堵塞小动脉和毛细血管。
阿司匹林可以抑制血小板活化,功能同样是防止血小板出现凝集。
我们可以发现,这两种药物并没有减少血液中各种物质的含量,仅仅是如同“润滑剂”一样,防止了较大团块的出现。这虽然在一定程度上降低了粘稠度,扩张了血管,暂时缓解了各种缺血的症状,但并 没有从根本上解决血液本身的问题 。
周女士在一次治疗过后,还需要定期摄入加强药效,正说明这种方法只是“缓解”而非“根治”。

并且,这两种药物长期大量服用,也会造成一定的副作用。
首先,阿司匹林作为一种常用药,有 明确的不良反应。
1. 刺激胃肠道 。造成上腹不适、恶心呕吐,严重时损伤胃粘膜,造成溃疡以及出血。
2.服用量大时影响中枢神经系统 ,造成头痛眩晕、耳鸣和视物模糊。这种症状与血粘度过高几位相似,如果分辨不清,继续加大药量,会对身体造成更大的损害。
3.慢性损害肝肾。 药品通过肝脏代谢解毒、肾脏过滤排出,长期大量服用对肝肾都会造成负担,肝脏在血检时会发现血清转氨酶升高,停药后可以恢复正常;肾脏可能表现为功能减退,严重者会出现肾炎。
其次,银杏达莫注射液作为一种处方药,与经常换用的丹参、川芎、舒血宁等药物,都常见于医院,有医生严格控制的药量和使用频率。长期不遵医嘱使用,容易造成血压过低,甚至让身体形成依赖,停药后反而对心脑血管有害。

总的来说,吴女士最初的处理是没有错的,但身体经过首次治疗后就会解除异常状态,之后自行调节,维持稳定。如果继续出现血稠和心脑血管疾病相关症状,就应当及时就医,查明病因,对症治疗。无论哪种情况, 此类药物“有病治病,无病防身”的用法是不可取的。
三、如何科学降低血粘度,预防心脑血管疾病?
根据上文的讲解,我们可以把 血液粘稠度过高的原因 归结为以下几点:
1. 血管里的“东西”太多。
2. 血液里的“水”太少。
3. 其它病理原因直接影响循环,降低血流速度。
4. 造血功能异常,血细胞形态受影响。

针对第一点,患者会在血常规化验中发现血糖或血脂过高。我们可以 通过降低血液中的胆固醇、纤维蛋白原和甘油三酯的含量 ,降低血粘度。
具体措施就是 控制饮食 ,控制摄入高糖分或过于油腻的食物,不吃小零食,适当运动,少食多餐,使身体的血糖血脂保持在一个平稳健康的状态。
针对第二点,我们可以 加强饮水 ,通过增加血液中的水来稀释过量的内容物。
具体需要注意的时间点有:运动后及时补水;起床及入睡前适量补水;三餐前一小时适量饮水(200毫升)。另外,建议使用体温左右的白开水,更加容易被人体吸收,也不会过冷刺激胃肠道。

针对第三、四点,患者应当 及时就医,查明病因, 通过治疗原发疾病和稀释血液*管双**齐下,用最有效的手段治疗疾病,防止并发症的发生和伤损。
血粘度高容易导致的疾病有 高血压、心脏病、脑梗、血管硬化等循环系统疾病,以及肝脏、肺部和乳腺部位的肿瘤。
不过,血粘度高 只是这些疾病的一个危险因素, 有一定的发病几率,但血粘度高只要及时发现,就好调节、易治愈,不必过分焦虑。
另外,通过一些物理手段来加速血液循环,也是保持血流通畅的有效方法。比如 轻负担的运动、泡脚或者跑热水澡 、排遣压力保持心情舒畅。都可以从一定程度上加速血液循环,保护心脑血管。

吴女士所在的诊所在了解情况之后,劝说她回到医院详细检查诊断,言明利害之后,吴女士欣然同意,解除了不少身体上的隐患。
结语:健康应当把握在自己的手中,时刻注意身体状况,作出合理应对,才能畅享健康舒适的生活。